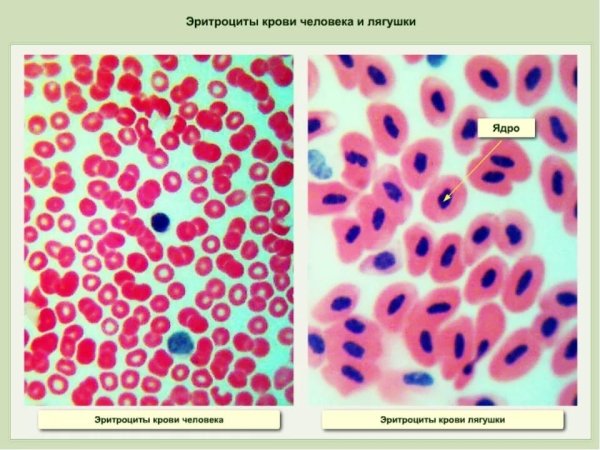
Микропрепарат крови лягушки под микроскопом

Эритроциты – это красные кровяные клетки, которые играют важную роль в организме человека. Они отличаются особым строением и функцией, что делает их уникальными. Внешне эритроциты представляют собой дискообразные клетки, лишенные ядра. Именно поэтому они могут свободно перемещаться по кровеносным сосудам и выполнять свою главную функцию – переносить кислород из легких во все ткани организма. Благодаря содержанию особого белка – гемоглобина – эритроциты способны связываться с кислородом, а затем доставлять его к клеткам, обеспечивая их жизнедеятельность. Этот процесс называется окислением и является неотъемлемой частью работы нашего организма. Таким образом, эритроциты можно сравнить с незаменимыми посредниками, обеспечивающими нашим тканям необходимое дыхание и поддержание жизненных функций.
Эритроцит рисунок строение
Строение эритроцитов
Строение эритроцитов человека рисунок
Строение эритроцитов человека и лягушки
Эритроцит схема строения
Строение эритроцита крови лягушки
Строение эритроцита лягушки
Строение эритроцита и гемоглобина
Строение эритроцитов в крови
Строение эритроцитов человека рисунок
Эритроциты человека
Кровяные клетки эритроциты
Форма и строение эритроцитов человека
Схема форменные элементы крови эритроциты лейкоциты тромбоциты
Форма клетки эритроцитов лягушки
Строение клетки крови эритроциты
Строение строение эритроцитов
Эритроциты биология 8 класс
Строение крови под микроскопом
Строение эритроцитов 8 класс
Эритроциты человека
Строение клетки крови лягушки под микроскопом
Строма эритроцита
Эритроциты биология 8 класс
Зарисуйте эритроцит
Эритроциты рисунок
Эритроциты особенности строения и функции
Строение клетки крови эритроциты
Эритроциты рисунок карандашом
Эритроцит черно белый
Мазок крови человека рисунок с обозначениями
Строение клетки эритроцита лягушки
Клетки крови лягушки рисунок
Строение эритроцитов лягушки рисунок
Клетки крови эритроциты лейкоциты тромбоциты рисунок
Строение эритроцита человека
Кровь эритроциты лейкоциты тромбоциты
Строение клетки крови эритроциты
Кровь лягушки под микроскопом и кровь человека
Строение эритроцита человека
Форма клеток крови человека и лягушки
Строение клетки крови лягушки под микроскопом
Строение крови лягушки
Строение эритроцита человека схема
Эритроциты крови человека рисунок
Микропрепарат крови лягушки под микроскопом
Эритроциты лейкоциты тромбоциты рисунок
Строение эритроцитов в крови человека

Grizly.club
Grizly.club